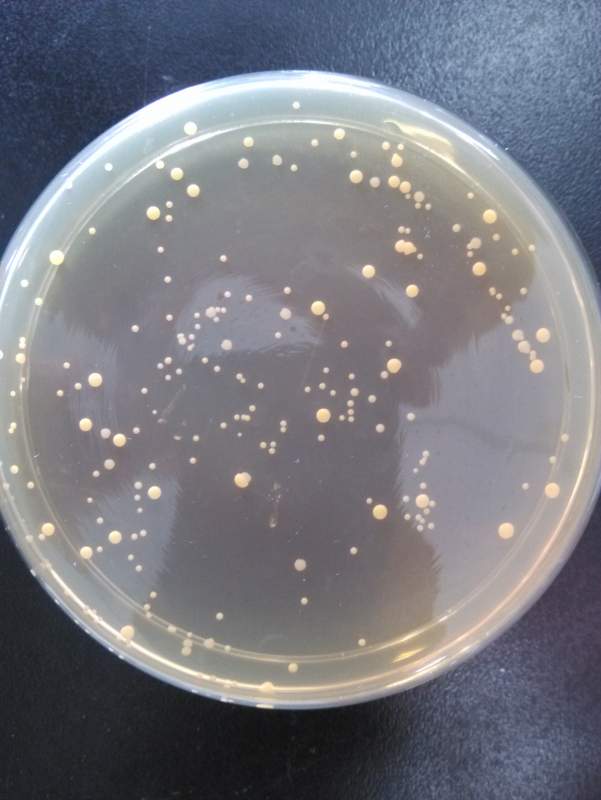
微生物在固体培养基上生长是否有延滞期

白腐真菌培养基图

图4-balf标本沙堡弱培养基27℃,培养5天后形成白色致密毛绒样菌落菌落
图片尺寸659x670
真菌培养基的配置初步
图片尺寸500x375
白腐菌(其他生物相关)白腐菌是属于担子菌亚门的真菌,因腐朽木材呈
图片尺寸400x300
这是什么菌啊培养基很清澈
图片尺寸1080x810
假单胞菌显色培养基,法国科玛嘉,科玛嘉显色培养基
图片尺寸400x400
一种促进白腐真菌挂膜的培养基制造技术
图片尺寸438x299
微生物在固体培养基上生长是否有延滞期
图片尺寸601x800
大家帮忙看下土壤分离的真菌要计数培养了三天成这样了怎么计数啊
图片尺寸451x800
求教真菌(培养基中)形态描述方法?(有图)
图片尺寸960x720
pda液体培养基接种真菌后颜色问题
图片尺寸600x450
求助用平板培养的真菌的图片
图片尺寸600x450
培养基上就出现一层白白的东西,请问谁知道白白的是细菌或者真菌或者
图片尺寸800x599
请问该真菌大致是什么菌?培养基上该菌的真面和反面如下图
图片尺寸600x649
土壤微生物培养,请大家帮我指出在这些培养皿中,怎么分辨细菌,真菌和
图片尺寸702x671
大家帮我看看pda培养基上那些小的点点是真菌的菌落吗
图片尺寸2336x4160
ttc-沙保罗培养基的应用
图片尺寸350x233
麦芽膏粉提供真菌生长所需的碳源,蛋白质和氮源;琼脂是培养基的凝固剂
图片尺寸1390x1632
大家帮我看看pda培养基上那些小的点点是真菌的菌落吗
图片尺寸4095x2299
一株兼具拮抗大蒜根腐病病原菌和促生功能的真菌
图片尺寸1757x1707
求鉴定液体培养基是否被细菌污染
图片尺寸800x599